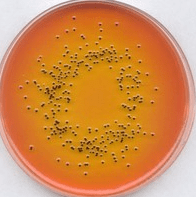
محیط کشت Lysine Decarboxylase Broth 1 محیط کشت Lysine Decarboxylase Broth

مشخصات محصول:
محیط کشت Lysine Decarboxylase Broth برای افتراق سالمونلا آریزونا از گروه Bethesda Ballerup انترو باکتریاسه می باشد. محیط های کشت دکربوکسیلاز در ابتدا توسط محققی بنام Moeller برای تشخیص لایزین و اورنیتین دکر بوکسیلاز و آرژنین دهیدرولاز طراحی شد. محقق دیگری بنام Falkow محیط کشت لایزین دکربوکسیلاز را برای تشخیص وافتراق سالمونلا و شیگلا طراحی کرد. این محیط کشت بخصوص بیشتر مناسب مطالعه واکنش های دکربوکسیلاز اعضای انتر و باکتریاسه می باشد نسبت به کلبسیلا و انتروباکتر. محیط کشت Lysine Decarboxylase Broth همچنین به وسیله APHA و سایر متدهای استاندارد توصیه شده است. در مراحل اولیه انکوباسیون، بعد از تلقیح، تخمیر دکستروز توسط ارگانیسم ها باعث تولید اسید می شود.واکنشی که باعث می شود رنگ بروموکروزول بنفش به رنگ زرد تغییر یابد. از طرفی این وضعیت اسیدی باعث تحریک فعالیت دکربوکسیلازی می شود که همین مسئله باعث دکربوکسیلاسیون لایزین به cadavarini می شود. وضعیت قلیایی ایجاد شده براثر تولید cadaverine باعث می شود رنگ اندیکاتور بروموکروزول بنفش که به رنگ زرد تغییر یافته بود، دوباره به بنفش تغییر یابد. در میکروارگانیسم هایی که آنزیم دکربوکسیلاز تولید نمی کنند، رنگ محیط کشت به رنگ زرد باقی می ماند.
ویژگیها و کاربردهای اصلی Lysine Decarboxylase Broth
تفکیک باکتریها: این محیط کشت به عنوان یک وسیله تشخیصی برای تمیز کردن و تفکیک باکتریهای مختلف مورد استفاده قرار میگیرد. باکتریهایی که قادر به دیکربوکسیلاسیون لیزین هستند، اسید آمینه لیزین را به اسپرمیدین تبدیل میکنند و باعث تغییر رنگ محیط میشوند.
- تشخیص اسید آمینه: با استفاده از این محیط، میتوان اسید آمینه لیزین و تولید اسپرمیدین توسط باکتریها را تشخیص داد. این میتواند در شناسایی و تفکیک میان باکتریهای مختلف کمک کند.
- مطالعه فعالیت باکتریها: از این محیط به عنوان یک ابزار مطالعه برای بررسی فعالیت باکتریها در تخریب لیزین و تولید اسپرمیدین استفاده میشود. این مطالعات میتوانند در درک عملکرد باکتریها و ویژگیهای آنها کمک کنند.
- آزمونهای تشخیصی: Lysine Decarboxylase Broth به عنوان یک محیط آزمون تشخیصی در آزمایشگاههای پزشکی و میکروبیولوژی مورد استفاده قرار میگیرد تا باکتریهای مشخصی را شناسایی کند.
در کل، Lysine Decarboxylase Broth یک محیط مخصوص در زمینه میکروبیولوژی است که به تشخیص و تمیز کردن باکتریها بر اساس فعالیتهای دیکربوکسیلاسیونی و تولید اسپرمیدین کمک میکند.